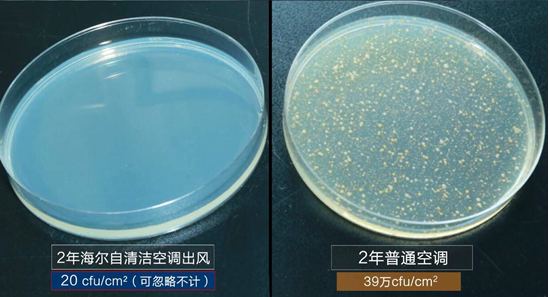

这家伙很懒,什么也没写!
盛夏全国各地普遍沦陷在高温天气中,许多家庭的空调也已经进入24小时运转模式。然而在享受空调带来的凉爽舒适时,用户也面临着脏空调困扰。有网友抱怨,空调开机后散发阵阵霉味,久吹空调还患上了空调病。
那么,空调多年不清洗到底有多脏?
6月13日,海尔空调入户跟踪实拍的一则清洗视频显示,使用多年的空调蒸发器染黑白手套,清洗后流出一盆黑水。中科院的一组细菌检测实验也显示:使用2年的普通空调蒸发器表面细菌数高达39万cfu/cm2。
事实上,脏空调内部藏污纳垢是由蒸发器的工作原理和特殊结构造成的。空调蒸发器是冷热空气交换的必经场所,潮湿的环境极易吸附细菌、灰尘、霉菌等。由于蒸发器呈翅片状,在阴暗潮湿处常年不见阳光,又成为细菌、霉菌繁殖的“乐园”。

长期不清洗的脏空调有哪些危害?
细菌、霉菌随空调开机进入室内,造成室内空气二次污染,可能会引起人体的呼吸系统、免疫系统疾病;长期不清洗的空调蒸发器被灰尘堵住,换热效率低,致使制冷、制热效果下降,增加耗电量;脏空调还会增加压缩机负荷,增大故障率,降低空调的使用寿命。

如何清洗家中脏空调?有以下两种可行方案:
一是人工深度清洗。在夏季、冬季开机前深度清洗空调蒸发器,将内部污垢清洗干净。选择这种方法,每次邀请专业服务人员清洗空调的费用大约100到200元不等。

二是选择自清洁空调,让空调随时给自己“洗澡”。这将从根本上避免空调内部脏、难清洗的问题。

海尔自清洁空调搭载专利自清洁6大创新技术,让冷凝水在蒸发器表面结霜化霜,强力剥离蒸发器污垢;化霜时,凝水技术增加30%的水量,结合强亲水性的宝石蓝涂层,能快速、彻底冲洗蒸发器表面污垢,吹出健康空气。






























参与讨论
评论列表 共有 0 条评论